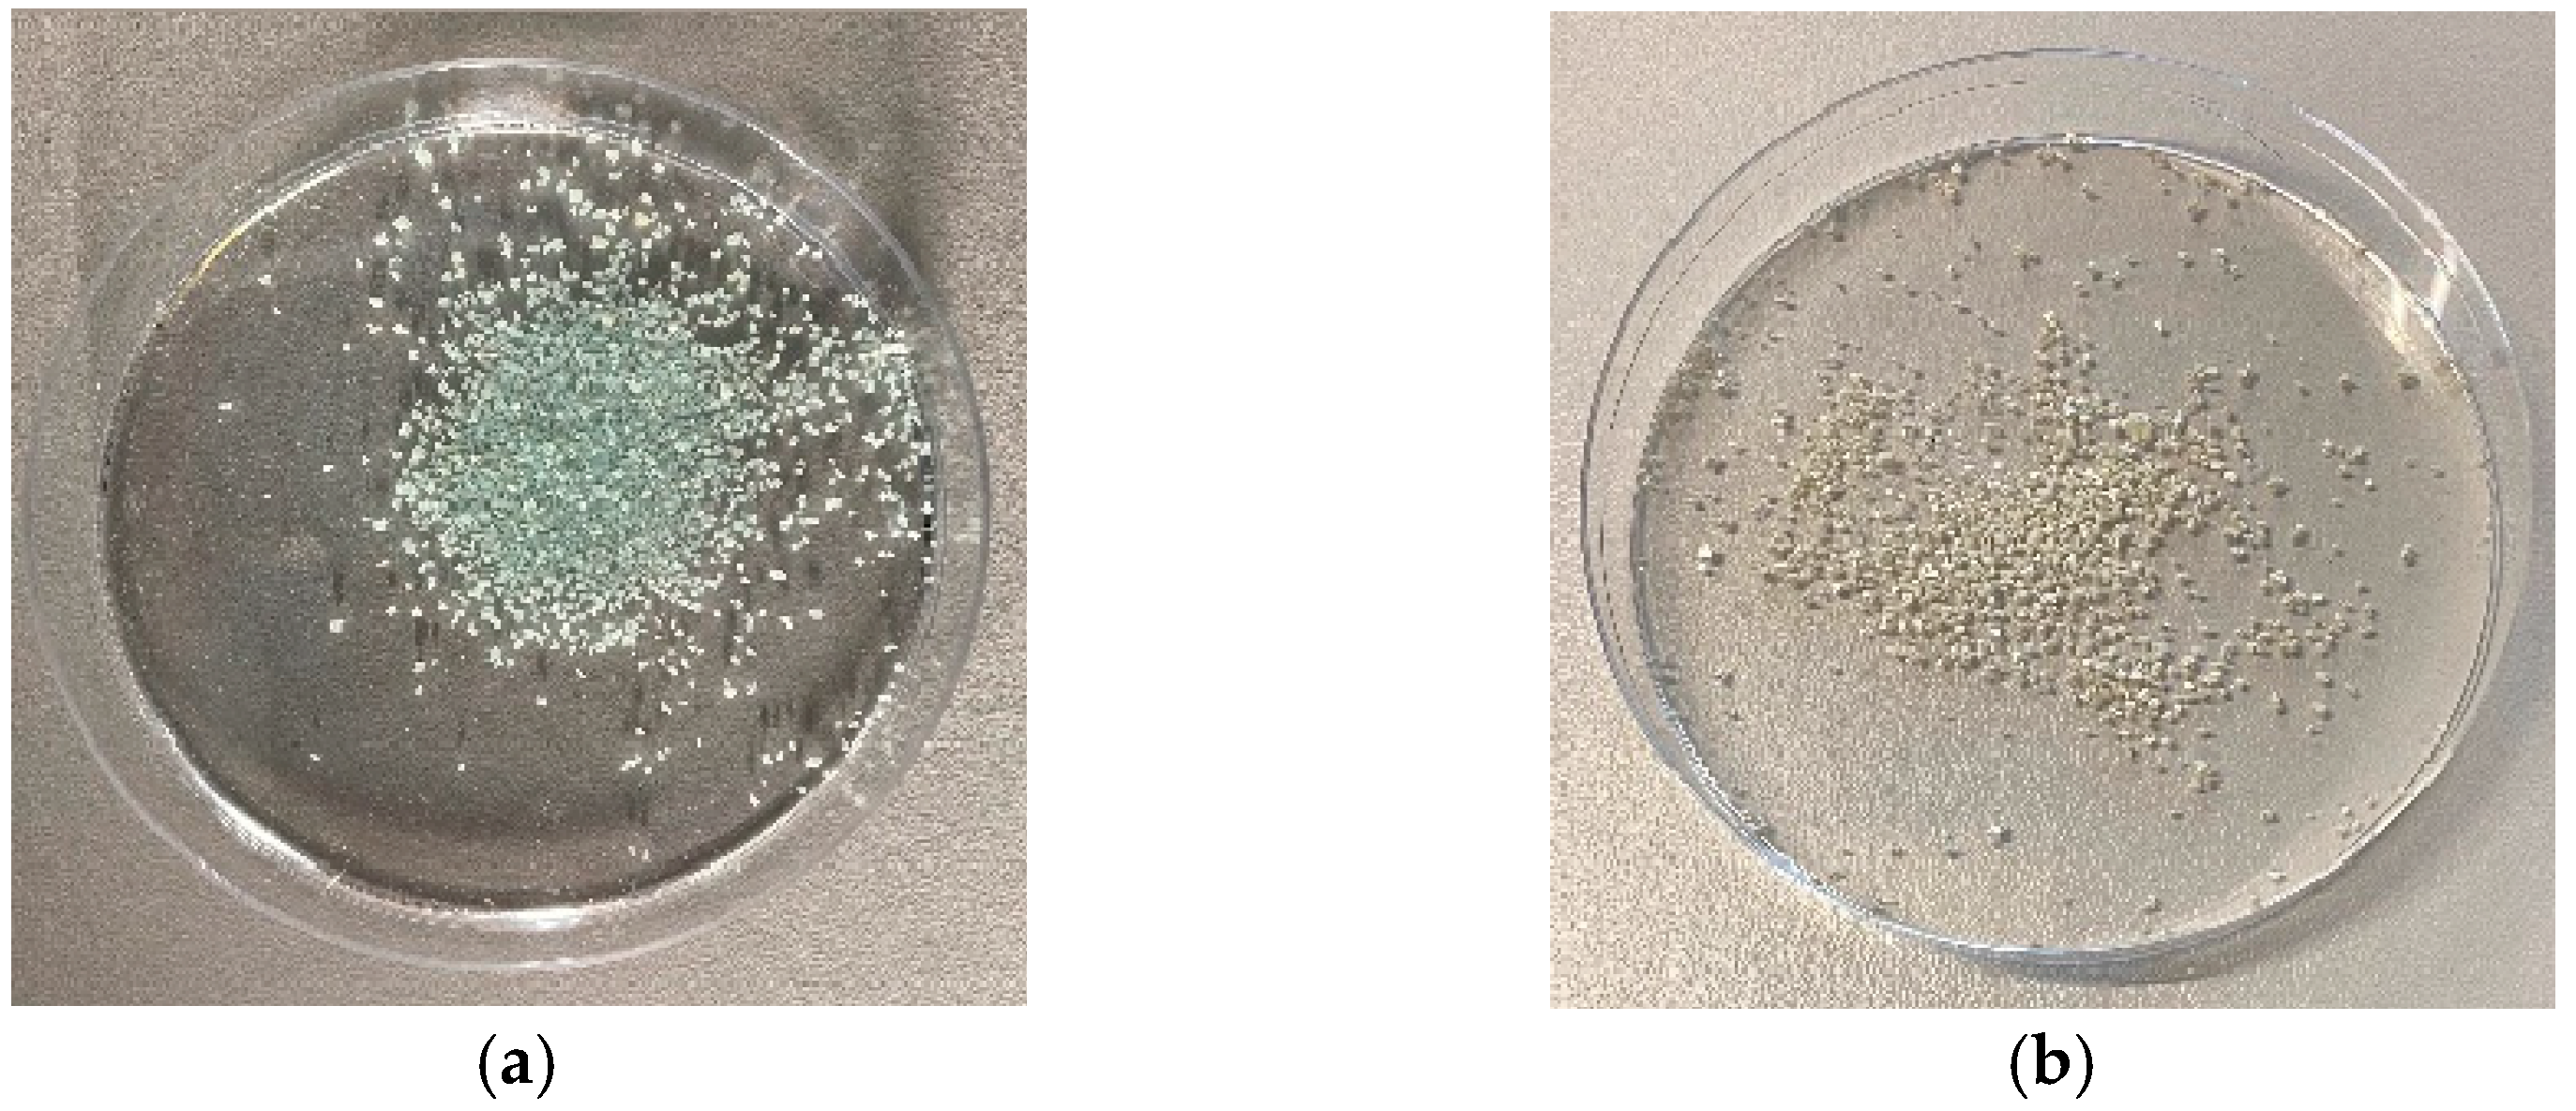
Materials 16 03221 g008

Low-Pressure Microwave Plasma Reduction of Iron and Copper Salt Compounds at Low Temperatures for Oxidation State Alteration and Functional Applications
Abstract
:1. Introduction
2. Materials and Methods
3. Results
3.1. Initial Oxidation and Reduction Plasma Tests with Metal Strips
3.2. Reduction of Oxidized Metals in Salt Compounds
3.3. Evaluation of the Reduction of the Low-Pressure Plasma-Treated Metal Salt Layers by XPS
4. Conclusions
- -
- Microwave ambient air plasma oxidized copper strips, while steel strips remained unchanged.
- -
- CuCl2 and FeSO4 crystals changed significantly with a Varigon plasma treatment.
- -
- A time-dependent reduction trend with Varigon plasma was observed on CuCl2 layers with a clear reduction from Cu2+ to Cu+ → hydrogen-containing microwave plasma reduced copper-salt layers.
- -
- The reduction of base metal salt layers (FeCl3 and FeSO4) in a Varigon plasma was successful by implementing an ambient air plasma pre-treatment → metal compounds with a lower standard electrode potential compared with hydrogen were reduced by hydrogen-containing plasma.
- -
- Surface activation effects and the influence of ambient air after treatment caused the reduction impact to decrease in the FeSO4 layers.
- -
- The plasma treatments succeeded at low temperatures between 30 °C and 50 °C.
Author Contributions
Funding
Data Availability Statement
Acknowledgments
Conflicts of Interest
References
- Bertini, I.; Gray, H.B.; Stiefel, E.I.; Valentine, J.S. Biological Inorganic Chemistry: Structure and Reactivity, 1st ed.; University Science Books: Sausalito, CA, USA, 2007. [Google Scholar]
- Wiberg, E.; Holleman, A.F. Lehrbuch der Anorganischen Chemie; De Gruyter: Berlin, Germany, 1971; pp. 71–80. [Google Scholar]
- von Metzen, R.P.; Stieglitz, T. The effects of annealing on mechanical, chemical, and physical properties and structural stability of Parylene C. Biomed. Microdevices 2013, 15, 727–735. [Google Scholar] [CrossRef] [PubMed]
- Sun, X.; Zheng, Y.; Peng, X.; Li, X.; Zhang, H. Parylene-based 3D high performance folded multilayer inductors for wireless power transmission in implanted applications. Sens. Actuators A Phys. 2014, 208, 141–151. [Google Scholar] [CrossRef]
- Chen, Q.; Wang, Z.; Lin, M.; Qi, X.; Yu, Z.; Wu, L.; Bao, L.; Ling, Y.; Qin, Y.; Cai, Y.; et al. Homogeneous 3D Vertical Integration of Parylene-C Based Organic Flexible Resistive Memory on Standard CMOS Platform. Adv. Electron. Mater. 2021, 7, 2000864. [Google Scholar] [CrossRef]
- Kwon, K.Y.; Sirowatka, B.; Weber, A.; Li, W. Opto- μECoG array: A hybrid neural interface with transparent μECoG electrode array and integrated LEDs for optogenetics. IEEE Trans. Biomed. Circuits Syst. 2013, 7, 593–600. [Google Scholar] [CrossRef] [PubMed]
- Li, W.; Rodger, D.C.; Meng, E.; Weiland, J.D.; Humayun, M.S.; Tai, Y.-C. Flexible Parylene Packaged Intraocular Coil for Retinal Prostheses. In Proceedings of the 2006 International Conference on Microtechnologies in Medicne and Biology, Okinawa, Japan, 9–12 May 2006; IEEE: Piscataway, NJ, USA, 2006; pp. 105–108. [Google Scholar]
- Lin, Y.-Y.; Evans, R.D.; Welch, E.; Hsu, B.-N.; Madison, A.C.; Fair, R.B. Low Voltage Electrowetting-on-Dielectric Platform using Multi-Layer Insulators. Sens. Actuators B Chem. 2010, 150, 465–470. [Google Scholar] [CrossRef]
- Maeng, J.; Kim, B.G.; Ha, D.; Chappell, W.J. In Proceedings of the 2011 IEEE MTT-S International Microwave Symposium-MTT 2011, Baltimore, MD, USA, 5–10 June 2011; held as part of Microwave Week 2011. IEEE: Piscataway, NJ, USA, 2011.
- Majid, N.; Dabral, S.; McDonald, J.F. The parylene-aluminum multilayer interconnection system for wafer scale integration and wafer scale hybrid packaging. J. Electron. Mater. 1989, 18, 301–311. [Google Scholar] [CrossRef]
- Teixeira, E.C.; Piascik, J.R.; Stoner, B.R.; Thompson, J.Y. Zirconia-parylene multilayer thin films for enhanced fracture resistance of dental ceramics. Proc. Inst. Mech. Eng. Part H J. Eng. Med. 2009, 223, 897–902. [Google Scholar] [CrossRef]
- Zehner, J.; Huhnstock, R.; Oswald, S.; Wolff, U.; Soldatov, I.; Ehresmann, A.; Nielsch, K.; Holzinger, D.; Leistner, K. Nonvolatile Electric Control of Exchange Bias by a Redox Transformation of the Ferromagnetic Layer. Adv. Electron. Mater. 2019, 5, 1900296. [Google Scholar] [CrossRef]
- Myochi, R.; Nagao, T.; Fugane, Y.; Takahashi, S.; Todoroki, N.; Wadayama, T. Oxygen Reduction Reaction Properties for Dry-Process Synthesized Pt/TaC x Nanoparticles. ECS Trans. 2018, 86, 519–524. [Google Scholar] [CrossRef]
- Ni, C.; Carolan, D.; Rocks, C.; Hui, J.; Fang, Z.; Padmanaban, D.B.; Ni, J.; Xie, D.; Maguire, P.; Irvine, J.T.S.; et al. Microplasma-assisted electrochemical synthesis of Co3O4 nanoparticles in absolute ethanol for energy applications. Green Chem. 2018, 20, 2101–2109. [Google Scholar] [CrossRef]
- Tasche, D.; Weber, M.; Mrotzek, J.; Gerhard, C.; Wieneke, S.; Möbius, W.; Höfft, O.; Viöl, W. In Situ Investigation of the Formation Kinematics of Plasma-Generated Silver Nanoparticles. Nanomaterials 2020, 10, 555. [Google Scholar] [CrossRef]
- Vos, C.d.; Baneton, J.; Witzke, M.; Dille, J.; Godet, S.; Gordon, M.J.; Sankaran, R.M.; Reniers, F. A comparative study of the reduction of silver and gold salts in water by a cathodic microplasma electrode. J. Phys. D Appl. Phys. 2017, 50, 105206. [Google Scholar] [CrossRef]
- Römermann, H.; Müller, A.; Bomhardt, K.; Höfft, O.; Bellmann, M.; Viöl, W.; Johannsmann, D. Formation of metal (nano-)particles in drying latex films by means of a reducing plasma: A route to auto-stratification. J. Phys. D Appl. Phys. 2018, 51, 215205. [Google Scholar] [CrossRef]
- Lee, S.W.; Liang, D.; Gao, X.P.A.; Sankaran, R.M. Direct Writing of Metal Nanoparticles by Localized Plasma Electrochemical Reduction of Metal Cations in Polymer Films. Adv. Funct. Mater. 2011, 21, 2155–2161. [Google Scholar] [CrossRef]
- Lee, S.W.; Janyasupab, M.; Liu, C.-C.; Sankaran, R.M. Fabrication of Ir nanoparticle-based biosensors by plasma electrochemical reduction for enzyme-free detection of hydrogen peroxide. Catal. Today 2013, 211, 137–142. [Google Scholar] [CrossRef]
- Haye, E.; Busby, Y.; Da Silva Pires, M.; Bocchese, F.; Job, N.; Houssiau, L.; Pireaux, J.-J. Low-Pressure Plasma Synthesis of Ni/C Nanocatalysts from Solid Precursors: Influence of the Plasma Chemistry on the Morphology and Chemical State. ACS Appl. Nano Mater. 2018, 1, 265–273. [Google Scholar] [CrossRef]
- Ghosh, S.; Hawtof, R.; Rumbach, P.; Go, D.B.; Akolkar, R.; Sankaran, R.M. Quantitative Study of Electrochemical Reduction of Ag+ to Ag Nanoparticles in Aqueous Solutions by a Plasma Cathode. J. Electrochem. Soc. 2017, 164, D818–D824. [Google Scholar] [CrossRef]
- Shin, D.H.; Bang, C.U.; Kim, J.H.; Hong, Y.C.; Uhm, H.S.; Park, D.K.; Kim, K.H. Treatment of Metal Surface by Atmospheric Microwave Plasma Jet. IEEE Trans. Plasma Sci. 2006, 34, 1241–1246. [Google Scholar] [CrossRef]
- Sabat, K.C.; Rajput, P.; Paramguru, R.K.; Bhoi, B.; Mishra, B.K. Reduction of Oxide Minerals by Hydrogen Plasma: An Overview. Plasma Chem. Plasma Process. 2014, 34, 1–23. [Google Scholar] [CrossRef]
- Chandana, L.; Subrahmanyam, C. Non-thermal discharge plasma promoted redox transformation of arsenic(III) and chromium(VI) in an aqueous medium. Chem. Eng. J. 2017, 329, 211–219. [Google Scholar] [CrossRef]
- Crowther, J.M.; Badyal, J.P.S. Cold Plasma Metallization of Supported Metal Salt Layers. Aust. J. Chem. 2012, 65, 1139. [Google Scholar] [CrossRef]
- Cui, W.; Wu, D.; Wang, W.-C.; Zhang, L.; Cao, B.; Jin, R. Surface-silvered polyimide films prepared by plasma-induced grafting of viologen and electroless plating. Surf. Coat. Technol. 2009, 203, 1885–1890. [Google Scholar] [CrossRef]
- Weber, M.; Vorobev, D.; Viöl, W. Microwave Plasma-Enhanced Parylene-Metal Multilayer Design from Metal Salts. Nanomaterials 2022, 12, 2540. [Google Scholar] [CrossRef]
- Martin, W.C.; Musgrove, A.; Kotochigova, S.; Sansonetti, J.E.; Kramida, A. Ground Levels and Ionization Energies for the Neutral Atoms, NIST Standard Reference Database 111. Available online: https://www.nist.gov/pml/ground-levels-and-ionization-energies-neutral-atoms (accessed on 16 February 2023).
- GESTIS-Stoffdatenbank. Entry of Copper(I)-oxide. Available online: https://gestis.dguv.de/data?name=004790 (accessed on 16 February 2023).
- GESTIS-Stoffdatenbank. Entry of Copper(II)-oxide. Available online: https://gestis.dguv.de/data?name=001990 (accessed on 16 February 2023).
- Suni, T.; Henttinen, K.; Suni, I.; Mäkinen, J. Effects of Plasma Activation on Hydrophilic Bonding of Si and SiO2. J. Electrochem. Soc. 2002, 149, G348. [Google Scholar] [CrossRef]
- Vasquez, R.P. CuCl by XPS. Surf. Sci. Spectra 1993, 2, 138–143. [Google Scholar] [CrossRef]
- Vasquez, R.P. CuCl2 by XPS. Surf. Sci. Spectra 1993, 2, 160–164. [Google Scholar] [CrossRef]
- Yamashita, T.; Hayes, P. Analysis of XPS spectra of Fe2+ and Fe3+ ions in oxide materials. Appl. Surf. Sci. 2008, 254, 2441–2449. [Google Scholar] [CrossRef]

| Reference | Category | Key Message |
|---|---|---|
| [1,2] | Basic principles of the redox state of iron and copper | Iron and copper exist in a variety of oxidation states in nature. The most prominent state for iron is iron(III) and for copper copper(II). |
| [3,5,9,10] | Parylene–metal multilayer system creation for semiconductor structures | Plasma was used to deposit conducting metal structures in nanometer scale within a semiconductor unit (silicon wafer, interposer, and CMOS) via sputter or beam deposition processes. |
| [4,6,7,11] | Parylene–metal material compounds for medical implants | Implants for electric conduction purposes and the increase in fracture resistance were designed from parylene metal multilayer systems. The deposition of metals was realized using sputtering processes. The multilayers are intended for use in retinal, brain, and dental implants. |
| [8,12] | Thin metal layers for electronic devices in combination with parylene layers (for references [8,9]) | Metal oxides (Ta2O5, FeOx) as examples of oxidized metals are included in electrical devices for electrowetting and ferromagnetic layers to manipulate exchange bias. |
| [13,14,15,16,17,18,19,20,21,25,26,27] | Plasma as a tool for the redox state alteration of metal compounds and thin films | Nanoparticles of various metal compounds (TaC, TaN, Ag, Au, Ir) were mostly synthesized from metal salt solution or directly from the elemental state by the application of plasma technology. This technology also causes reductive changes in thin films of oxidized metals. |
| [22,23,24] | Examination of the plasma mode of functioning on several metal compounds | A mixture of argon and hydrogen gases causes the highest change in aluminum surfaces. Atomic hydrogen provides a better plasma reduction effort, and the plasma influences solved metal salts via the generation of hydrogen peroxide, hydroxyl radicals, and hydrated electrons. |
| Sample | Cu 2p3 [at.%] | Fe 2p3 [at.%] | O 1s [at.%] | C1s [at.%] |
|---|---|---|---|---|
| Cu (reference) | 0.55 | 2.01 | 2.10 | |
| Cu (air plasma) | 17.80 | 10.27 | 8.38 | |
| Fe (reference) | 0.27 | 2.66 | 3.34 | |
| Fe (air plasma) | 1.21 | 3.23 | 1.95 |
Disclaimer/Publisher’s Note: The statements, opinions and data contained in all publications are solely those of the individual author(s) and contributor(s) and not of MDPI and/or the editor(s). MDPI and/or the editor(s) disclaim responsibility for any injury to people or property resulting from any ideas, methods, instructions or products referred to in the content. |
© 2023 by the authors. Licensee MDPI, Basel, Switzerland. This article is an open access article distributed under the terms and conditions of the Creative Commons Attribution (CC BY) license (https://creativecommons.org/licenses/by/4.0/).
Share and Cite
Weber, M.; Scheglov, A.; Dörries, W.; Meyer, J.B.; Viöl, W. Low-Pressure Microwave Plasma Reduction of Iron and Copper Salt Compounds at Low Temperatures for Oxidation State Alteration and Functional Applications. Materials 2023, 16, 3221. https://doi.org/10.3390/ma16083221
Weber M, Scheglov A, Dörries W, Meyer JB, Viöl W. Low-Pressure Microwave Plasma Reduction of Iron and Copper Salt Compounds at Low Temperatures for Oxidation State Alteration and Functional Applications. Materials. 2023; 16(8):3221. https://doi.org/10.3390/ma16083221
Chicago/Turabian StyleWeber, Mirco, Anna Scheglov, Wiebke Dörries, Johann Benedikt Meyer, and Wolfgang Viöl. 2023. "Low-Pressure Microwave Plasma Reduction of Iron and Copper Salt Compounds at Low Temperatures for Oxidation State Alteration and Functional Applications" Materials 16, no. 8: 3221. https://doi.org/10.3390/ma16083221
APA StyleWeber, M., Scheglov, A., Dörries, W., Meyer, J. B., & Viöl, W. (2023). Low-Pressure Microwave Plasma Reduction of Iron and Copper Salt Compounds at Low Temperatures for Oxidation State Alteration and Functional Applications. Materials, 16(8), 3221. https://doi.org/10.3390/ma16083221

